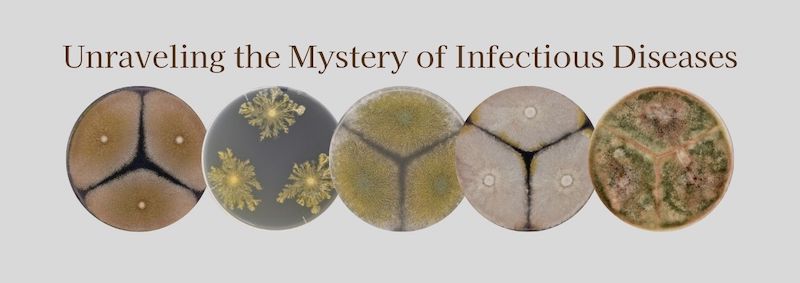
head_img

Research
 Our laboratory explores the molecular foundations of pathogenic fungi. We aim to clarify how the host immune system responds to fungal infections, reveal the mechanisms by which fungi develop drug resistance, and develop innovative therapeutic strategies based on genomic data.
As the number of immunocompromised patients continues to rise, fungal infections are becoming an increasingly serious public health issue. To address this challenge, we investigate how fungi interact with and evade the host immune system, and examine the molecular basis of antifungal drug resistance emerging in clinical settings.
Our laboratory explores the molecular foundations of pathogenic fungi. We aim to clarify how the host immune system responds to fungal infections, reveal the mechanisms by which fungi develop drug resistance, and develop innovative therapeutic strategies based on genomic data.
As the number of immunocompromised patients continues to rise, fungal infections are becoming an increasingly serious public health issue. To address this challenge, we investigate how fungi interact with and evade the host immune system, and examine the molecular basis of antifungal drug resistance emerging in clinical settings.
Furthermore, by using genomic analysis with next-generation sequencing technologies, we are uncovering genetic networks that underlie diversity, evolutionary adaptation, and drug resistance of pathogenic fungi. This work not only enhances diagnostic accuracy and supports the development of personalized medicine, but also contributes to the discovery of new therapeutic targets. Building on these findings, we aim to translate molecular-level insights into clinical applications, helping to develop innovative strategies for combating fungal infections.
News & Topics
2025.11. 4 Dr.Guido Puccetti has joined our lab as an postdoctoral researcher/JSPS
2025.10.30 Assistant Professor Shibata gave a talk at the 25th Yeast Joint Symposium.
2025.10.27 Research paper by Ms.Lu was published on Microbiol Spectrum
2025.10. 3 Prof. Takahashi, Assistant Professor Shibata presented a poster at the 69th Annual Meeting and Scientific Conference of the Japanese Society for Medical Mycology.
2025.10. 1 Associate Professor Takahashi has been promoted to full professor.
2025. 9.19 Assistant Professor Shibata and Assistant Professor Uchida presented a poster at the 31st Annual Meeting of the Japanese Society for Microbial Resources.
2025. 9. 3 Ms. Tatesaka and Ms.Lu presented a poster at the 58th Research Report Meeting of the Yeast Genetics Forum.
2025. 7.10 Research paper by Associate Professor Takahashi was published on Journal of Global Antimicrobial Resistance
2025. 7. 4 A press release about the paper has been posted on the university website."Uncovering the Hidden Emerging Pathogen Behind Aspergillosis Cases in Japan"
2025. 7. 3 An article by Associate Professor Takahashi has been posted on the university website.「CHIBADAI NEXT」
2025. 6.10 Research paper by Assistant Professor Shibata has been published in Medical Mycology
2025. 5.16 Associate Professor Takahashi,Assistant Professor Shibata,Assistant Professor Uchida and Ms.Tatesaka presented a poster at the 69th Annual Meeting of the Mycological Society of Japan.
2025. 4. 1 Associate Professor Takahashi will now serve concurrently in the Faculty of Science at the Chiba University
2025. 3. 3 Associate Professor Takahashi presented at the 17th European Conference on Fungal Genetics
Recruitment
We welcome applications from postdoctoral researchers and graduate students.If you are interested in our research, please feel free to contact us by email.
Contact to :
Prof. H.Takahashi.
hiroki.takahashi[at]chiba-u.jp Please send e-mail replacing [at] with @

